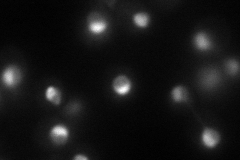
YKL082C
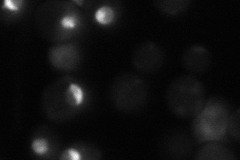
YKL082C
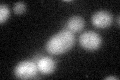
YKL082C

View description
Essential protein, constituent of 66S pre-ribosomal particles; interacts with proteins involved in ribosomal biogenesis and cell polarity; member of the SURF-6 family
Localization:
Intensity:
Fold change:
Significance:
-
C’ GFP library in SD

below threshold16.55 -
N' NOP1pr-GFP in SD
nucleolus86.6964 -
N' TEF2pr-mCherry in SD

nucleus,nucleolus93.8782 -
N' NATIVEpr-GFP in SD
nucleus,nucleolus36.279 -
N' TEF2pr-VC and Cyto-VN in SD

#N/A0 -
C’ GFP library in SD+DTT
cytosol17.091.03No -
C’ GFP library in SD+H2O2

cytosol17.921.08No -
C’ GFP library in Starvation Media

cytosol17.771.07No -
C’ GFP library on the background of Pup2-DaMP

below threshold -
C’ GFP library on the background of CCT mutant

below threshold16.38510.989558No
